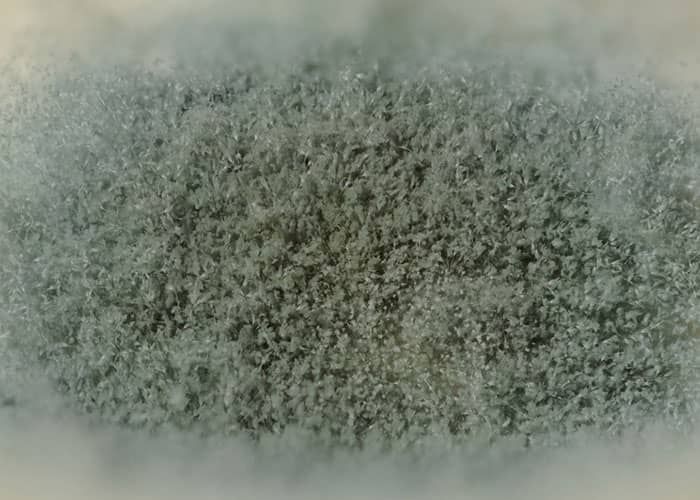

Stealing food from the office fridge is one of the most frustrating things a coworker can do. It’s rude, inconsiderate, and feels like a personal betrayal.
It also happens more often than you’d think—about 1 in 6 people admit to sneaking a bite from someone else’s lunch. Sure, you could report it to HR, but some employees prefer to take matters into their own hands. Like the ones on Reddit, who shared clever and wickedly hilarious ways they got back at their food-thieving coworkers. Scroll down to see their revenge stories, and don’t forget to upvote your favorites!
#1

I didn’t specially order the food in spite but one day I catered a huge order from a popular bbq place and didn’t tell the coworker who stole people's lunches (more than once from several people)
When he came down to the break room and he saw most of the company in there enjoying the food he asked why nobody told him. I looked over at him and said “we’ve been starving all week because someone keeps stealing lunches from the fridge, you never seem to complain about it so I didn’t think you were hungry.”
#2

We had an employee who stole food & drinks all the time. Let’s call her Erica since that’s her name.
She had a habit of stealing my single-serve yogurts from the fridge. I used a syringe to inject ghost chili oil into a strawberry “fruit on the bottom” cup. What she thought was strawberry “juice” instead made her mouth burn, her eyes water, and made her vomit.
I stayed late at the office that evening, fished the offending yogurt cup out of her trash, and deposited it in her top drawer so that she knew that “someone” was watching her.
#3

More than 25 years ago, I worked at a factory and about a few weeks prior, I started to notice a snack missing from my lunch. Some days it was just my potato chips, but it had started to become the cookie every day. Just one, as my wife would normally pack me two. I asked around and of course nobody knew anything.
The only out of the ordinary thing going on at the place was a very rotund and arrogant young man that had started about a month earlier, about the same time that I noticed bits of my lunch had gone missing. He had also said that it wasn’t him.
So I came up with a devilish idea. I made a big batch of chocolate chips cookies and brought them in for everyone to enjoy, except for two larger cookies that had an entire box of chocolate exlax baked face down into into them, which remained in my lunchbox.
It was the Wednesday before thanksgiving and my shift started at 11pm that night. I passed out the regular cookies to everyone at work to set the trap. 1am, nothing. Both cookies were still in my lunchbox. Oh well, I keep working.
3am rolls around and one of the cookies is missing. I joyfully go around telling everyone what I had done and to keep an eye on the restroom for the perpetrator. He should be easy to spot since he will likely be sprinting.
4am, I return to my workstation to realize the 2nd cookie was now missing. Uh, yeah I didn’t expect that they would take both cookies. It was usually just one. Whoever the suspect is now had enough exlax to propel the to the stratosphere.
5am, nothing yet but everyone’s eyes are on the restroom.
6:15am, this streak of safety gear wearing a hard hat comes bolting from the corner of the plant, screaming in agony and busts through the restroom door. It was indeed the young rotund probationary employee.
Everyone had a good laugh and a couple of coworkers decided to stand outside of the stall door and harass this poor young man. “I’ll bet you’ll never steal anyone’s lunch again kiddo”. “Now you’ll be spending Thanksgiving on the can. Your mama can slide your dinner under the door for you”.
The kid still denied it was him. Nobody believes it though, but my lunch was never messed with again.
#4

I still remember a story told by one of my Aunts when I was a kid. Her lunch kept disappearing from the refrigerator at work. She made a nice looking sandwich with good bread, lettuce, tomato etc, and a good layer of canned dog food in the middle of all that. Found the thief when they started barfing mid-sandwich. You don’t mess with Aunt Shirley, or her lunch.
#5

I like spicy food, really spicy food, like I regularly put scorpion pepper on a lot of my dishes.
I started making breakfast sandwiches and this guy at work kept eating them. I asked him to stop, told him those were not communal (because we do share coffee/creamer and stuff like that), but told him I’d be happy to prep him some since that’s something I do. Next day he comes in and heats one up and I said nothing. That night I made 2 burritos and put 1/2 of a scorpion pepper in each one, put my homemade habenaro pepper salsa on them, and used a Carolina reaper pepper hotsauce as well.
After 30 minutes in the bathroom he never ate my food again. Little B***h.
#6

I made a blindingly hot curry.
The funny part is that he had me dragged into the facility manager's office for 'booby trapping' my lunch.
I ate a forkful like it was no big deal and then pointed out to the manager that, if he was okay with stealing from his coworkers, then he'd definitely be okay with stealing from the company.
They started doing random bag checks after that and that guy always got his back checked when it happened.
#7

Interesting the amount of payback, but little questioning as to why someone may be stealing food. We had that happen at a company I worked for about 8 years ago. Rather than accusing or getting angry, we sent a company wide email and told the person that if they were dealing with food insecurity there was help. Invited them to reach out for help and provided additional resources. Unsure who it was or if they got the help they needed, but no food was stolen after.
#8

I never got revenge but I did get him to stop. It was baby sister’s idea actually.
I placed a clean, still in the wrapper, tampon on the top of the food in the paper bag. He never touched my stuff again.
#9

I followed an example from OITNB. I took a tampon and dipped in food coloring. Slipped it into a decoy sandwich (I kept my actual lunch in my office that day). Right before lunchtime I stood in the alcove near the lunchroom and watched a student slink into the lunchroom and come out with my little brown bag. He went into the student dining area and I followed at a safe distance. The look on his face when he bit into the sandwich and pulled a tampon out of his mouth was f*****g priceless. I never left my food in there again but I bet he never stole anything from there again, either.
Edit: I keep snacks and food items in my office specifically for students. They all know they can get food from me if they need it, theh just have to come by. Zero questions asked. Idc about the food, it’s the theft that pisses me off.
#10

I am a creature of habit and will often eat the same foods for a while before I get tired of them and switch to something else. It was usually a fruit or vegetable, so I kept it in the fridge until I wanted to eat it.
One busybody coworker would “help” by cleaning the fridge, but not tell anyone or give warning. Multiple times, she’d throw my snack away (clearly labeled) because, “It’s been there for days!” No amount of explaining that I just brought the same snack daily and, indeed, ate it daily would help. I even started putting the date on the bag next to my name and she still kept throwing out my snacks.
She also was a perpetual dish leaver in the break room sink. Maybe she used the same bowl every day and kept adding more bowls daily, but it really seemed like she would leave her dishes in the sink all week before cleaning them on Fridays before leaving for the weekend.
So I started throwing her dishes in the trash can on Thursday.
#11

I had a coworker steal a mango smoothie from the fridge. Long story short, I knew without a doubt that she was the one who stole it, yet she denied it regardless. It was probably a $5 smoothie, and I couldn’t have actually cared less about the smoothie itself, but was annoyed by the blatant lying about it. After she left work at the end of the day. I stole the M, A, N, G, and O keys off of her keyboard. I placed them in the fridge where my mango smoothie previously resided, strategically to spell out MANGO upon opening the fridge. I don’t think she found it particularly funny the next day when she arrived to the office with an incomplete keyboard, but to me, it was the perfect, humerous revenge.
#12

The one who stole my food would loudly tell everyone about their peanut allergy any time sharing food was involved. She stole my lunch so many times shamelessly, so one day I put some peanut butter cookies in my lunch. She stopped stealing my lunch after that.
#13

A guy at my old job was stealing food from fridges, and was caught nicking food from the kitchens too (we were a food manufacturer company)
Our Facilities Manager locked down his pass key so he couldn’t access certain places without a chaperone. Toilet and in-out the building was fine, but the kitchen and canteen he needed to be let in. He left soon after.
#14

I worked for a family business many years ago, used to have this huge office area, I’d keep Costco boxes of snacks in a drawer.
Noticed they were being taken, talked to the owners and convinced them to allow me to setup a hidden camera.
Caught a cleaner guy on video coming to eat my snacks, then as he’s eating he’s looking at my pictures, picks his nose and possibly wipes it on my chair.
I showed the video to the owners and the guy was fired within a few minutes.
#15

Revenge isn’t gonna keep my food safe. I bought a stainless steel box that took up a bunch of fridge space and kept my things under lock and key. HR tried calling me on it once but since I wasn’t about to start an escalating prank war of capsaicin, chemical bittering agents, or food poisoning they elected not to argue with “Someone was stealing from me. Now they can’t”.
#16

At my former job, we had a fridge bandit. This person would pick the tidbits out of your food. Example the shrimp out of your Chinese. However their biggest trait was taking sandwiches out of lunch boxes. After dealing with multiple employee complaints, and being a telecom, communications company I asked for cameras in the break room. My request was denied. So, vigilante action came into play. I spoke with three of the food victims and instructed them to meet me in my office the next day fifteen mins before their shift. When they showed up I had a loaf of bread and two cans of wet cat food. We made some new sandwiches to replace the ones in their lunch boxes. I had them remove the real sandwiches to store in my office refrigerator.
The culprit took the bait, and one of the sandwiches was stolen. We never saw who, but after that day, there wasn’t another theft before I moved on to another company and promotion. Petty and gross, but I love thinking about the big first bite they took and the reaction that followed. Lesson learned !
#17

I got tired of having sandwiches stolen so made a turkey sandwich and let it sit on the counter for a couple days before taking it in. Sure enough, it disappeared and someone had to leave early that day because they got sick. Never owned up to stealing it and thefts did seem to stop.
#18

Back in the day, someone kept stealing my Diet Cokes out of the office fridge. So I took a Mentos and put a needle and thread thru it, and carefully strung up the Mentos in the cap of a soda bottle. Sure enough it got stolen and when the thief opened it, the Mento fell in the Diet Coke and the whole thing exploded all over him, his desk, keyboard, monitor etc. There was a big commotion around his cubicle and I went over to see what was going on, knowing full well what had happened.
I went back to his desk about an hour later and I whispered to him “if you ever steal my soda again, I’ll break your f*****g legs and then I’ll get you fired.”
Problem solved
#19

I put a hidden camera in the fridge… caught him redhanded on camera diggin through everyones lunches. Then i sent a mass email to everyone in the office with the title found the office rat! He quit a few days later because everyone hated him and treated him bad after… karmas a b***h louie
#20

Not revenge, per se, but defense…
I kept an entire Costco box full of Häagen Dazs ice cream bars in the freezer for over a month, untouched, in a covered 9X13 casserole pan labeled “Enchiladas” ¯\_(ツ)_/¯
Nobody likes old soggy enchiladas.
#21

I kept a cup with candy in my office for myself and others, but someone was emptying the whole thing when I was at lunch. So I bought some hot Warheads and filled my cup with them, and warned my regular visitors about it. Came back from lunch, empty cup. About an hour later, there is an incoherent yell of pain and shock, and the freaking PARTNER OF THE LAW FIRM storms into my office and demands to know what kind of candy they were and complaining that they were horrible. Never mind she made (at least) 5x my salary and stealing all my candy, it was me who was in the wrong. But…she never took my candy again.
#22

I was having this type of issue and I like spicey food. So I made a roast beef sandwich with lettuce, tomato etc and I slathered on horse radish sauce. Just the way I like it.
The whole office actually heard the lunch thief scream after eating some of my lunch.
My boss was upset with me for the spicey sandwich. So I asked "Why are you supporting stealing from employees by another employee?"
Stealing of lunches stopped. Plus, whenever anyone saw the lunch their in the lunch room, he was watched like he was still stealing.
#23

Not me but my StepDad.
He used to LOVE to make pickled eggs and bring them into the mill to share with his friends. He would have them in a huge jar, and he would make around 100 eggs at a time. They were stored in a communal fridge. He started to see massive amounts disappearing, so he started to put notes on the jar like, "Please ask before you take an egg." Still, tones of eggs were disappearing. He heard who was doing it, and the culprit was taking them home.
So, he pi*sed in the jar. Gross, but the eggs were still being taken by this one dude. So, he waited until they were all gone, stood up in the lunchroom, and told the crew what he had done. Tones of laughs while the guy ran to the bathroom to puke.
Gross as hell, but no one touched his eggs ever again.
#24
This happened to a friend of mine. She would leave her sandwich in the communal fridge. Every day it got taken.
Finally she got a plastic bag printed with mold on it.
Nobody touched that sandwich again.
#25

Mixed a ton of red food coloring into a small amount of ketchup and spread on sandwich. Caught red toothed. May not work with people who brush their teeth.
#26

Informed them that my medication was mixed in with my food, told them that I wasn’t exactly sure what my seizure medication would do to someone who didn’t have seizures and that they may need to visit the ER.
Basically I lied. I was on meds and they were the kind that you sprinkled over something soft that you didn’t chew to take them but they were in my purse waiting for me to take them with yogurt. The thief had taken my clearly labeled sandwich but left my yogurt alone.
#27

Made a tomato based sauce with lots of fresh basil and mixed a tablespoon of Da Bomb hotsauce to it. The dude suffered bad.
#28

A classic. Ghost pepper dust in the burger. This was about 9 years ago, I was working at Walmart and pregnant. I would often get Jr. Chicken or big mac before my shift, and leave it in the fridge for lunch. I started to notice it going missing, so I started leaving a note on it. It still happened. Management did nothing, wouldn’t even check the cameras. Ordered some dried ground ghost peppers online, and put a butt ton of it under the patty on the jr chicken. Heard from a few co-workers some girl we worked with who everyone disliked, ran out of the lunch room bawling and was seen in the bathroom with her mouth under the faucet.
#29

Laced my lunch with ghost pepper—watched the thief turn redder than our company’s budget report!
#30

I left 2 pieces of pizza in the fridge. I removed the cheese layer carefully and dumped a ton of salt on top of the sauce and put the cheese back on top.
#31
I had a co-worker who kept stealing my fresh apple cider and red beans and rice, so the next time I made RBnR I made it so blazing hot I could barely stand it (yet authentically cajun), and I put a note on the apple cider saying that it was a urinalysis sample. Poor taste perhaps, but at this point, I was tired of the company saying ‘suck it up and just forget about it’
I didn’t personally see the reaction, but I did witness her running down the hall, and I heard screaming and saying her eyes and mouth were on fire. She apparently turned into a ball of snot and tears for hours, while I sat in my cube, building software, quietly smiling in my head.
She never touched anyone’s stuff there again and retired shortly after that.
#32
I love hot sauce. I dont have a limit to hotness. I love to sweat and push my limits. I already had an idea of who was eating my food because they were sweating inside of a cool grocery store.
So I ordered some Hot Ones The Last Dab Xperience.
I put it in my macaroni goulash I made one day. That was the day an ambulance showed up because the dude thought he was going to spontaneously combust. Pretty much admitted while he was being checked out and asked me how the hell do I consume that c**p. Asked me right in front of my manager. Told him to buy his own food and experiment for himself.
He never stole food again.
#33
A couple of years ago I used to take a 1 litre carton of strawberry flavoured milk with me to work. I’d drink half of it and put the rest in the breakroom fridge for the next day. Then all of a sudden the carton would be empty and it happened several times. So one time after drinking half of the milk I went back to breakroom when everyone was back to work. I spit in the carton a few times, gave it a good shake and put it back in the fridge. The next day it was empty again. Just before the first coffee brake I went to the breakroom and put a note on the fridge saying I spit in my milk, hope you liked the taste! Everyone comes in for coffee and one of the metal guys reads the note and immediately starts gagging and got super pissed and the entire company knew who the guilty one was. After that I took an insulated bottle with me (the keep the milk cold) that I kept in my locker because I wasn’t about the take the risk of him spitting in my milk and me drinking it.
#34
I always crave sweets after lunch, and my coworker kept stealing my donuts and sliced cake. At first, I thought it was an honest mistake and was trying to be nice, so I let it slide. But it kept happening. So, my best friend made a pot brownie, and I let my coworker eat it. After an hour, her eyes were red, and she was completely on cloud nine. Someone called HR, and she didn’t come to work the next day.
#35

My granddad put laxatives in some brownies, then told his boss what he did. So the boss sends the guy on a business trip to a city that's about 2 hours away. A 4 hour trip going there and back took him like 10 hours.
#36
I used to work for a company in Newcastle (UK) where a man was arrested and fired for stealing biscuits from a colleagues desk during night shift. His excuse was that he believed they were bought by the company for staff consumption. He was given 12 months conditional discharge, £150 court costs and had to pay for the costs of the biscuits. (£7 Marks and Spencers selection box)
#37

Wasabi! Got a burger off the truck. Cut out the middle and filled it with Wasabi. ( Japanese horse radish) Put it back in the little foam box and wrote ” My lunch, do not take”.
SOB tried to down it in two bites. You could here him screaming from the far side of the building.
Took him out in an ambulance. He was unharmed. ROFLMAO He was fired.
#38
Ex lax in my chocolate brownie….in a call centre for AT&T. Took 45 minutes and they s**t themselves while running for the bathroom.
The person who stole my lunch constantly and others…was my manager. He tried to fire me. I went to HR and told them what I did. He got fired. I stayed..:D
Yummy? mmmmm? Taste good the brownies? ha ha (my exact words to the manager in front of HR)
#39
I made a salami sandwich generously spread with Vegemite. Buddy ol’pal must have though it was bbq sauce or else.. Never came back for my food !
And for Aussies out there I’m not saying that stuff isn’t tasteful but to the unprepared European taste it’s quite awful.
#40

I had some cupcakes that were stolen. The next time the cupcakes were filled with shaving cream.
#41
Worked at a place where there was a donut thief. Department rivalry played a part in the theft. Maintenance group emptied out a crème filled donut and refilled it with grease; put it back in the fridge. No more donut thefts.
#42
Red food coloring in my chili. Found them real quick.
#43
Worked with a guy who brought 2 Powerades to work everyday. Kept one with him, the second went in a shared refrigerator. Everyday he went to get the second one, someone had drank half of it and just put it back. Finally, he drank half of it before work, filled it back up with p**s and put it in the fridge. When he went to check on it later, about a third of it was missing, but not half. After that day, his Powerade was never touched again.
#44
I left my lunch on top on my truck in the Florida heat then placed it in the fridge. It didn’t take long to identify the suspect…
#45
Kept happening on a regular basis. Eventually, I made some pasta with a c**p ton of California reapers blended into the sauce. They stopped for a while after this.
#46

Not me, but my dad, during the 1970s. Some dude kept stealing lunches from the breakroom fridge. Management wouldn’t do anything about it. So one day my dad made a peanut butter and dog s**t sandwich, wrapped it up and put it in a lunch bag in the fridge.
Not only does the food thief steal the s**t sandwich, he eats half of it while my dad watched before figuring out what was going on. Then he stood up and started screaming blue murder. The thief was outraged, and complained to management. Management said “don’t steal lunches then” and that was it for official reprisals.
Every other worker there started calling the thief “s**t eater” for the rest of his time there.
#47
Only packed things he was allergic to. Soy, for example. He didn’t know my sandwich was tofurkey and didn’t read the label for the bottle of Silk chocolate soy milk that carefully.
#48
Bit of washing up liquid mixed gently in the sauce.
#49
Made a “lunch” out of spoiled chicken. The security guard was out sick for 2 days. I guess he thought no one would suspect him. Even when he returned, he was pale as a ghost.
#50
Found out who did it by waiting until everyone left for the day and walked around the entire office looking in everyone’s trash cans until I found remnants of what used to be my $3 frozen microwave meal. It could’ve been an honest mistake, but I don’t even care. The following day I took the license plate off of her car and threw it into the dumpster.
#51
First time was ham cheese, lettuce and Carolina Reaper. Good for a month. Second time, I taped a $2 coin to my sub and asked them to steal my money, not my lunch. No more problems. Guilt > mouth pain?
#52

I worked with a guy who had someone stealing his food at work but he worked overnight so there was nowhere to go when his food was missing. He said he mixed a little s**t into some potato salad and left it out overnight. Then packed it into a decoy lunch. The thief was so sick with massive food poisoning he went to the hospital. I thought that was fair.
#53

A co-worker of mine noticed someone was drinking his lemonade. Went to the men’s room and filled the container with a liquid that appeared to be lemonade, but was not.
#54
I still had the receipt and I sent her an invoice and cc:ed her boss. A few days later I dumped her Tupperware full of lunch in the trash.
#55
I wouldn’t call mine “revenge”
It was after Thanksgiving, so I’d bought a plate of leftovers.
I put them in the fridge at the office (call center work) before my shift started, lunch rolled around and my lunch was gone…
looked around, nothing…until something behind the ice machine caught my eye! It was my plate! tossed behind the ice machine!
I sent out a company wide email calling out the person, let them know it was pretty low of them, that if they had some kinda beef with me that I wasn’t hard to find…
…I was fired shortly after that…they claimed I wasn’t verifying zip codes on addresses during my calls 🙄🙄🙄
#56
I labeled my food with fake warnings about being spicy or expired. No more stolen lunches!
#57
I have several, albeit slightly vague, subtle tips, one of which I often used on my labels, that the food may contain residues from my pet’s medications, but as I got used to it, no difference is noticeable, however, another person may react medically or allergically, and that they should then urgently call emergency services.
#58

I had yogurt tubes in the freezer that kept disappearing one at a time during night shift. I had a few boxes of them, I took them out of the freezer and left them in a drawer for a month and then put them back in the freezer. They all got eaten over the next few weeks, I never heard if someone got sick by the internet told me they start to spoil in only a few hours.
#59
Someone was stealing my coworker’s gatorade everyday, he would bring 2 in and drink one at lunch then the other with dinner and every day the second one was missing when he went to eat his dinner. So he filled one up with laxatives and put it in the fridge after lunch. At dinner time it was missing and he checked in the bathroom to see who was having a bad day, told the guy “don’t steal my gatorade anymore or this will happen again.”
#60
I didn't have a co-worker just steal my food, but had my lunch thrown in the trash which was even worse!! I was a new hire, so I just started working there, so the look on my face from not finding my paper brown bag in the fridge, panicking thinking someone ate it, to seeing it unwrapped, open, and thrown in the trash amongst coffee grounds on top (therefore unsaveable) was like a huge slap to my face like wtf!!?!?!? Not only did I not have anything to eat, but would have to suffer another 5-6 hours on an empty stomach, because that hellhole only gave us 15min for lunch. Bruhhhh I'm not one for confrontation, but this wasn't just any lunch, it was leftovers from my trip to Austin and I had gotten it from my favorite taco place.
I went back into the workroom filled with people I barely knew holding my tears back from fuming so hard like "Hey who threw away my lunch??" Yo everyone was so quiet and looked around cuz that's just preposterous and messed up in general. Took a long time for one of them to meekly speak up and said they thought it was old so they threw it away. I was irritated but told him "It says 4/20 on it because that's the name of the taco labeled on the bag." He thought it was someone's old food since it was September at the time even though I had placed it right in the middle of the fridge that morning. He was so embarassed and bought me Taco Bell to make up for it. Smh….that did not make up for it lemme tell you. Now I know not to put anything in the fridge that have numbers written on them just in case.
#61
Once a co- worker stole my food and literally had guts to admit it. So once i mixed tremendous amount of salt and chilli in food and then i made him eat that . That day was diabolical.
#62
Cleaning fridge out and got some old leftovers that should be thrown out, bring them to work instead and label it with a name. Let them get sick from food poisoning.
#63

**Take some powdered milk and rub it into the fabric of their office chair.**
Try to put lots on. It’ll take a lot. For example, just take any office chair and smack it with your hand 10 times in the same spot and see how much dust billows out of it. They’re basically a powder sponge.
The powdered milk won’t really do anything … … at first.
But, combined with the heat and moisture of their asses sitting on it, it will gradually impress itself into their clothing, and go rancid.
**It will go rancid very, very slowly, such that they are nose blind to it.**
A little more every day, it will start to stink and stink.
No one will tell them. How do you approach that topic? “Gee, over the last month you’ve started smelling rotten more and more”? Of course not.
But what the victim will discover is that people find opportunities to avoid them. They won’t get invited out. People will not make eye contact in the hallways. People will look for ways to get out of conversation with them. They’ll feel socially isolated out of awkward tension and politeness.
The victim will wonder what act of theirs caused everyone to hate them. What people found out about that they’re not mentioning.
And how can the victim address it with anyone else? If they can even put their finger on the fact that they’re not being treated as well?
This works especially well for men, as men tend to only have a half-dozen pairs of pants or suit jackets to switch among, and aren’t drycleaning them unless soiled. Wool pants and jackets in particular are going to sponge up the stench.
IF they suspect it’s something about the clothes, or if they suspect it’s a smell and they buy new clothes, or dryclean their clothes, it won’t matter. The chair itself is holding the rotting powder, it’ll keep being renewed by them sitting in it. It’s a solid Plan B that they think their own body is the source, which is stinking up their clothes, not the chair. They’ll try perfumes and deoderants, they’ll be self-conscious about their diet. The amount of head-space “you stink” occupies will be just as impactful to them as not knowing about it.
**Then, after two months of this… do nothing.** You never tell him.
F**k ’em. It’ll erode their confidence, their self-worth, undermine their career and their assertiveness. They’ll become shy and timid. If they’re single they’ll never get a successful date.
All for like, $0.80 in powdered milk.
